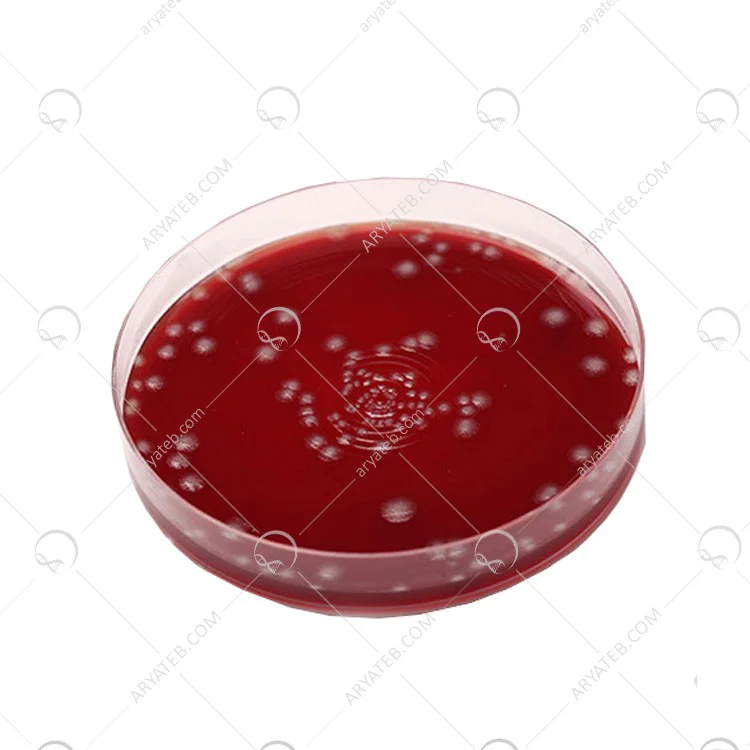

محیط کشت بروسلا آگار( (Brucella Agar
محیط کشت بروسلا آگار یا محیط کشت بروسلا آگار یک انگل داخل سلولی است که باعث سقط جنین در حیوانات و سپسیس یا عفونت های موضعی استخوان، بافت یا سیستم اندام در انسان می شود. این گونه های بروسلا بسیار خسته کننده هستند و بنابراین برای رشد به محیطی غنی از مواد مغذی نیاز دارند. علاوه بر این، گونههای بروسلا بسیار مسری هستند و باید با احتیاط فراوان درمان شوند.
محیط کشت بروسلا آگار با مکمل ها برای غنی سازی، جداسازی و کشت گونه های بروسلا یا کمپیلوباکتر از نمونه های بالینی و غیر بالینی توصیه می شود.
محیط بروسلا آگار یک محیط اصلاح شده است که برای حمایت از رشد سریع سایر باکتری های سریع رشد مانند استرپتوکوک، پنوموکوک، لیستریا، نایسریا مننژیتیدیس و هموفیلوس آنفولانزا فرموله شده است.

توضیحات و خلاصه محصول
BRU آگار یک محیط غیر انتخابی غنی شده است که از رشد میکروارگانیسم های سختگیر پشتیبانی می کند. آگار BRU حاوی کازئین، پپتون، عصاره مخمر و دکستروز به عنوان محیط پایه مغذی است. این مکمل با ویتامین K1 و هیمین برای تسهیل بازیابی و تولید رنگدانه Prevotella melaninogenica و سایر بی هوازیهای سختگیر است. خون گوسفند برای فاکتورهای رشد مورد نیاز برخی از باکتریهای بیهوازی اضافه شده است و امکان مشاهده واکنشهای همولیتیک را میدهد، همانطور که بوسیله بتا همولیز ناحیه دوگانه کلستریدیوم پرفرنجنس مشاهده میشود. این محیط در شرایط بدون اکسیژن تهیه، توزیع و بسته بندی می شود تا از تشکیل محصولات اکسید شده قبل از استفاده جلوگیری شود.
روش و طرز تهیه محیط کشت بروسلا آگار
43گرم بروسلا آگار را در یک لیتر آب تصفیه شده معلق کنید.
آن را با هم زدن مکرر حرارت دهید و یک دقیقه بجوشانید تا محیط کاملا حل شود.
اتوکلاو در دمای 121 درجه سانتیگراد به مدت 15 دقیقه.
در ظروف پتری استریل بریزید.
از روش های استاندارد برای به دست آوردن کلنی های منفرد استفاده کنید.
از آنجایی که بسیاری از پاتوژن ها برای جداسازی اولیه به دی اکسید کربن نیاز دارند، صفحات تا دمای 35 2 2 درجه سانتیگراد گرم می شوند.
با دی اکسید کربن در محیط هوازی به مدت 72-24 ساعت جوجه کشی کنید
ذخیره سازی و ماندگاری محصول
پس از دریافت، در دمای اتاق در بسته بندی اصلی تا زمان استفاده نگهداری شود. از گرم شدن بیش از حد یا یخ زدگی خودداری کنید. در صورت وجود علائم زوال (چروکیدگی، ترک خوردن، یا تغییر رنگ به دلیل اکسیداسیون محیط) یا آلودگی، از رسانه استفاده نکنید. تاریخ انقضا برای محصول در بسته بندی اصلی آن اعمال می شود و طبق دستورالعمل ذخیره می شود. از تاریخ انقضای نشان داده شده روی برچسب محصول گذشته استفاده نکنید.
خرید محیط کشت بروسلا آگار
محدودیت های استفاده از محیط کشت بروسلا آگار
بروسلا آگار برای استفاده در تشخیص بیماری یا سایر شرایط در انسان در نظر گرفته نشده است.
به دلیل تنوع غذاها، برخی از سویه ها ممکن است در این محیط رشد خوبی داشته باشند یا نشوند.
همه موجودات بی هوازی ممکن باید با آزمایش تاییدی شناسایی شوند
آدرس ایمیل شما منتشر نخواهد شد. فیلدهای الزامی علامت گذاری شده اند *